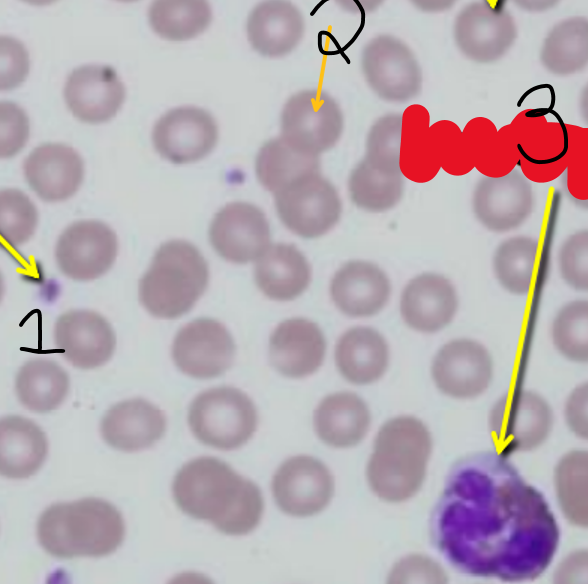
term image
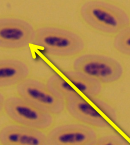
<p>quelle est la structure pouinté</p>

1/24
identification des structures
Name | Mastery | Learn | Test | Matching | Spaced |
|---|
No study sessions yet.

1- trachée 2- poumons 3- péricarde (contenant le coeur) 4- médiastin

1- oreillette droite 2- Base 3- ventricule droit 4- apex 5- oreillette gauche 6- sillon interventriculaire 7- ventricule gauche

1- veine cave crâniale 2- artère coronaire 3- vaisseaux interventriculaires 4- tronc pulmonaire 5- artère pulmonaire gauche 6- aorte

1- oreillette droite 2- ventricule droit 3- artère interventriculaire 4- aorte 5- tronc pulmonaire 6- oreillette gauche 7- ventricule gauche

1- oreillette gauche 2- ventricule gauche 3- oreillette droite 4- ventricule droit 5- sillon interventriculaire

1- aorte 2- veines pulmonaires 3- veine coronaire 4- veine interventriculaire 5- veine cave caudale 6- artère coronaire 7- artère coronaire

1- oreillette droite 2- valve pulmonaire 3- valve tricuspide 4- cordage tendineux 5- ventricule droit 6- septum interventriculaire 7- oreillette gauche 8- valve mitrale 9- muscle papillaire 10- ventricule gauche

1- épicarde 2- valve aortique (non visible ) 3- endocarde 4- myocarde

1- artère carotide (gauche) 2- veine sous-clavière 3- veines brachiocéphaliques 4- veine cave 5- veines pulmonaires

1- artère carotide droite 2- veine jugulaire droite 3- veine sous-clavière droite 4- veine cave 5- veine axillaire gauche 6- tronc brachiocéphalique

10 veine brachiocéphalique gauche 2- veine jugulaire gauche 3- artère auxillaire droite 4- artère céphalique droite 5- veine céphalique gauche

1- artères carotides 2- artère sous-clavière droite 3- artère sous-clavière gauche 4- tronc brachiocéphalique 5- crosse aortique 6- coeur

1- veine cave caudale 2- aorte abdominale 3- artères iliaques externes

1- veine surrénale gauche 2- veine rénale gauche 3- artère rénale droite 4- veine génitale (ovarienne) droite 5- artère génitale (ovarienne) gauche

1- aorte abdominale 2- artère iliaque interne gauche 3- artère coccygienne (ou caudale) 4- artère iliaque

1- veine cave caudale 2- veines iliaques communes

1- glande surrénale gauche 2- veine surrénae gauche 3- veine rénale gauche 4- artère rénale gauche 5- veine cave caudale 6- veine génitale (ovarienne) droite 7- aorte abdominale

1-veine surrénalienne gauche 2- veine rénale droite 3- veine ovarienne droite 4- veine cave caudale 5-artère fémorale 6- veine fémorale droite 7- veine iliaque commune droite

1- veine cave caudale 2- aorte abdominale 3- artère iliaques externes 4- artères iliaques internes

1- artère iliaque externe gauche 2- artère fémorale gauche 3- veine fémorale gauche

1-adventice 2- média 3- intima
qu’est-ce qui est a droit et qu’est-ce qui est a gauche
droite - artère gauche - veine

quelle est la structure pointé dans l’image
capillaire
1- thrombocyte 2- érythrocyte 3- leucocyte
quelle est la structure pouinté
érythrocyte (nucléé)